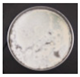
Pathogens 14 00162 i002
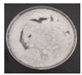
Pathogens 14 00162 i004
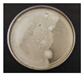
Pathogens 14 00162 i006
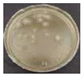
Pathogens 14 00162 i008
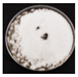
Pathogens 14 00162 i033
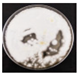
Pathogens 14 00162 i034

Phytotoxic and Antifungal Effects of Plantago major and Sambucus nigra Bioextracts on Key Agricultural Pathogens: Corynespora cassiicola, Fusarium oxysporum, and Penicillium oxalicum
Abstract
1. Introduction
2. Materials and Methods
2.1. Collection of Plant Material and Processing and Extraction of Bioextracts via Continuous Maceration
2.2. Fungal Species
Molecular Identification
2.3. Antifungal Activity
2.3.1. Standardization of the Inoculum
2.3.2. Minimum Inhibitory Concentration (MIC) and Minimum Fungicidal Concentration (MFC)
2.4. Effect of Bioextracts on Spore Germination
2.5. Phytotoxicity Assay
Germination Bioassay
2.6. Identification of Bioactive Compounds by UPLC-PDA-ESI-MS
2.7. Statistical Analysis
3. Results
3.1. Identification and Extraction of Plant Material
3.2. Antifungal Activity
3.2.1. Effect of Methanolic Leaf Bioextracts of Plantago Major (MBPm)
3.2.2. Effect of Methanolic Root Bioextracts of Sambucus Nigra (MBSn)
3.3. Phytotoxicity Assay: Germination Parameters
3.4. Major Polyphenolic Compounds: Identification by UPLC-PDA-ESI-MS/MS
4. Discussion
5. Conclusions
Author Contributions
Funding
Institutional Review Board Statement
Informed Consent Statement
Data Availability Statement
Acknowledgments
Conflicts of Interest
References
- Matrose, N.A.; Obikeze, K.; Belay, Z.A.; Caleb, O.J. Plant extracts and other natural compounds as alternatives for post-harvest management of fruit fungal pathogens: A review. Food Biosci. 2021, 41, 100840. [Google Scholar] [CrossRef]
- Cenobio-Galindo, A.d.J.; Hernández-Fuentes, A.D.; González-Lemus, U.; Zaldívar-Ortega, A.K.; González-Montiel, L.; Madariaga-Navarrete, A.; Hernández-Soto, I. Biofungicides Based on Plant Extracts: On the Road to Organic Farming. Int. J. Mol. Sci. 2024, 25, 6879. [Google Scholar] [CrossRef]
- Pasupuleti, M.K.; Nagate, R.R.; Alqahtani, S.M.; Penmetsa, G.S.; Gottumukkala, S.N.V.S.; Ramesh, K.S.V. Role of medicinal herbs in periodontal therapy: A systematic review. J. Int. Soc. Prev. Community Dent. 2023, 13, 9–16. [Google Scholar] [CrossRef]
- Liu, D.; He, X.Q.; Wu, D.T.; Li, H.B.; Feng, Y.B.; Zou, L.; Gan, R.Y. Elderberry (Sambucus nigra L.): Bioactive compounds, health functions, and applications. J. Agric. Food Chem. 2022, 70, 4202–4220. [Google Scholar] [CrossRef]
- Rumpunen, K. Water and ethanol extracts of Plantago major leaves show anti-inflammatory activity on oral epithelial cells. J. Tradit. Complement. Med. 2018, 9, 169–171. [Google Scholar] [CrossRef]
- Adom, M.B.; Taher, M.; Mutalabisin, M.F.; Amri, M.S.; Abdul Kudos, M.B.; Wan Sulaiman, M.W.A.; Sengupta, P.; Susanti, D. Chemical constituents and medical benefits of Plantago major. Biomed. Pharmacol. 2017, 96, 348–360. [Google Scholar] [CrossRef] [PubMed]
- Ghanadian, M.; Soltani, R.; Homayouni, A.; Khorvash, F.; Jouabadi, S.M.; Abdollahzadeh, M. The effect of Plantago major hydroalcoholic extract on the healing of diabetic foot and pressure ulcers: A randomized open-label controlled clinical trial. Int. J. Low Extrem. Wounds 2022, 19, 15347346211070723. [Google Scholar] [CrossRef]
- Stępień, A.E.; Trojniak, J.; Tabarkiewicz, J. Health-promoting properties: Anti-inflammatory and anticancer properties of Sambucus nigra L. flowers and fruits. Molecules 2023, 28, 6235. [Google Scholar] [CrossRef] [PubMed]
- Kartini, P.; Piyaviriyakul, S.; Thongpraditchote, S.; Siripong, P.; Vallisuta, O. Effects of Plantago major extracts and its chemical compounds on proliferation of cancer cells and cytokines production of lipopolysaccharide-activated THP-1 macrophages. Pharm. Mag. 2017, 13, 393–399. [Google Scholar] [CrossRef] [PubMed]
- Liu, Q.; Xiong, X.; Lin, H.; Zhang, L.; Chen, N.; Liu, X.; Liu, T. Antifungal effect of cinnamon essential oil against Penicillium oxalicum on rice noodles. J. Food Sci. 2024, 89, 6638–6652. [Google Scholar] [CrossRef]
- Xu, J.; Gong, G.; Cui, Y.; Zhu, Y.; Wang, J.; Yao, K.; Chen, W.; Wu, C.; Yang, R.; Yang, X.; et al. Comparison and correlation of Corynespora cassiicola populations from kiwifruit and other hosts based on morphology, phylogeny, and pathogenicity. Plant Dis. 2023, 107, 1979–1992. [Google Scholar] [CrossRef] [PubMed]
- Hudson, O.; Fulton, J.C.; Dong, A.K.; Dufault, N.S.; Ali, M.E. Fusarium oxysporum f. sp. niveum molecular diagnostics: Past, present, and future. Int. J. Mol. Sci. 2021, 22, 9735. [Google Scholar] [CrossRef] [PubMed]
- Lam-Gutiérrez, A.; Ayora-Talavera, T.R.; Garrido-Ramírez, E.R.; Gutiérrez-Miceli, F.A.; Montes-Molina, J.A.; Lagunas-Rivera, S.; Ruíz-Valdiviezo, V.M. Phytochemical profile of methanolic extracts from Chilca (Baccharis glutinosa) roots and its activity against Aspergillus ochraceus and Fusarium moniliforme. J. Environ. Biol. 2019, 40, 302–308. [Google Scholar] [CrossRef]
- Deresa, E.M.; Diriba, T.F. Antifungal activities of phytochemicals: A review of botanical fungicides against phytopathogenic fungi. Heliyon 2023, 9, e13810. [Google Scholar] [CrossRef]
- Lam-Gutiérrez, A.; Ayora-Talavera, T.; Garrido-Ramírez, E.R.; Ruíz-Valdiviezo, V.M.; Guzmán-Albores, J.M.; Cristóbal-Alejo, J. Chemical composition and antifungal activity of essential oils extracted from Pimenta dioica and Piper auritum leaves grown in Mexico. Cogent Food Agric. 2024, 10, 1. [Google Scholar] [CrossRef]
- Cruz-Cerino, P.; Cristóbal-Alejo, J.; Ruiz-Carrera, V.; Carnevali, G.; Vera-Ku, M.; Martín, J.; Reyes, F.; Gamboa-Angulo, M. Extracts from six native plants of the Yucatán Peninsula hinder mycelial growth of Fusarium equiseti and F. oxysporum, pathogens of Capsicum chinense. Pathogens 2020, 9, 827. [Google Scholar] [CrossRef] [PubMed]
- Hoil Cocom, P.A. Inhibitory Activity of the Aqueous Extract of Bonellia flammea Against Postharvest Fungi of Capsicum spp. Master’s Thesis, Instituto Tecnológico de Conkal, Conkal, Mexico, 2016. [Google Scholar]
- Moo-Koh, M.; Hernández, M.; Bosque, E. Actividad in vitro del extracto acuoso de Bonellia flammea contra hongos fitopatógenos. Agrociencia 2014, 48, 835–840. [Google Scholar]
- Ullah, N.; Haq, I.-U.; Mirza, B. Phytotoxicity evaluation and phytochemical analysis of three medicinally important plants from Pakistan. Toxicol. Ind. Health 2013, 31, 389–395. [Google Scholar] [CrossRef] [PubMed]
- Moreno, B.N.E.; Miranda, D.; Martínez, M.F.E. Germinación de semillas de anón (Annona squamosa L.) sometidas a estratificación. Rev. Colomb. Cienc. Hort. 2013, 7, 20–30. [Google Scholar] [CrossRef]
- Herrera-Pool, E.; Ramos-Díaz, A.L.; Lizardi-Jiménez, M.A.; Pech-Cohuo, S.; Ayora-Talavera, T.; Cuevas-Bernardino, J.C.; García-Cruz, U.; Pacheco, N. Effect of solvent polarity on the ultrasound-assisted extraction and antioxidant activity of phenolic compounds from habanero pepper leaves (Capsicum chinense) and its identification by UPLC-PDA-ESI-MS/MS. Ultrason. Sonochem. 2021, 76, 105658. [Google Scholar] [CrossRef] [PubMed]
- Monagas, M.; Brendler, T.; Brinckmann, J.; Dentali, G.; Gafner, S.; Giancaspro, G.; Johnson, J.; Kababick, J.; Ma, C.; Oketch-Rabah, H.; et al. Understanding plant to extract ratios in botanical extracts: Definitions, misconceptions, and implications for quality assurance. Front. Pharmacol. 2022, 13, 981978. [Google Scholar] [CrossRef] [PubMed]
- Zhakipbekov, K.; Turgumbayeva, A.; Issayeva, R.; Kipchakbayeva, A.; Kadyrbayeva, G.; Tleubayeva, M.; Akhayeva, T.; Tastambek, K.; Sainova, G.; Serikbayeva, E.; et al. Antimicrobial and other biomedical properties of extracts from Plantago major, Plantaginaceae. Pharmaceuticals 2023, 16, 1092. [Google Scholar] [CrossRef] [PubMed]
- Astuti, A.D.; Etikawati, N.; Pangastuti, A. Antibacterial activity of Plantago major leaves against Streptococcus pyogenes ATCC 19615 as a cause of tonsillitis. Asian J. Trop. Biotechnol. 2020, 17, 14–21. [Google Scholar]
- El-Baky, N.A.; Amara, A.A.A.F. Recent approaches towards control of fungal diseases in plants: An updated review. J. Fungi 2021, 7, 900. [Google Scholar] [CrossRef]
- Schoss, K.; Kočevar Glavač, N.; Dolenc Koce, J.; Anžlovar, S. Supercritical CO2 plant extracts show antifungal activities against crop-borne fungi. Molecules 2022, 27, 1132. [Google Scholar] [CrossRef] [PubMed]
- Hasan, M.; Ahmad-Hamdani, M.S.; Rosli, A.M.; Hamdan, H. Bioherbicides: An eco-friendly tool for sustainable weed management. Plants 2021, 10, 1212. [Google Scholar] [CrossRef] [PubMed]
- El-Mergawi, R.A.; Al-Humaid, A.I. Searching for natural herbicides in methanol extracts of eight plant species. Bull. Natl. Res. Cent. 2019, 43, 22. [Google Scholar] [CrossRef]
- Yadav, A.; Singh, S.; Yadav, V. Screening herbal extracts as biostimulants to increase germination, plant growth and secondary metabolite production in wheatgrass. Sci. Rep. 2024, 14, 607. [Google Scholar] [CrossRef] [PubMed]
- Weir, T.L.; Park, S.-W.; Vivanco, J.M. Biochemical and physiological mechanisms of allelochemical action in plants. Curr. Opin. Plant Biol. 2004, 7, 472–479. [Google Scholar] [CrossRef] [PubMed]
- Li, J.; Chen, L.; Chen, Q.; Miao, Y.; Peng, Z.; Huang, B.; Guo, L.; Liu, D.; Du, H. Allelopathic effect of Artemisia argyi on the germination and growth of various weeds. Sci. Rep. 2021, 11, 4303. [Google Scholar] [CrossRef]
- Rossi, R.; Mainardi, E.; Vizzarri, F.; Corino, C. Verbascoside-rich plant extracts in animal nutrition. Antioxidants 2023, 13, 39. [Google Scholar] [CrossRef]
- Zhou, Y.; Zhu, J.; Shao, L.; Guo, M. Current advances in acteoside biosynthesis pathway elucidation and biosynthesis. Fitoterapia 2020, 142, 104495. [Google Scholar] [CrossRef] [PubMed]
- Pendota, S.C.; Aderogba, M.A.; Ndhlala, A.R.; Van Staden, J. Antimicrobial and acetylcholinesterase inhibitory activities of Buddleja salviifolia (L.) Lam. leaf extracts and isolated compounds. J. Ethnopharmacol. 2013, 148, 515–520. [Google Scholar] [CrossRef]
- Luo, J.; Wang, K.; Li, G.S.; Lei, D.Q.; Huang, Y.J.; Li, W.D.; Chen, Y.Q.; Kong, J.L. 3,5-Dicaffeoylquinic acid disperses Aspergillus fumigatus biofilm and enhances fungicidal efficacy of voriconazole and amphotericin B. Med. Sci. Monit. 2018, 24, 427–437. [Google Scholar] [CrossRef] [PubMed]
- Pliszka, B. Polyphenolic content, antiradical activity, stability, and microbiological quality of elderberry (Sambucus nigra L.) extracts. Acta Sci. Pol. Technol. Aliment. 2017, 16, 393–401. [Google Scholar] [CrossRef]
- Mazu, T.K.; Bricker, B.A.; Flores-Rozas, H.; Ablordeppey, S.Y. The mechanistic targets of antifungal agents: An overview. Mini Rev. Med. Chem. 2016, 16, 555–578. [Google Scholar] [CrossRef] [PubMed]
- Steglińska, A.; Bekhter, A.; Wawrzyniak, P.; Kunicka-Styczyńska, A.; Jastrząbek, K.; Fidler, M.; Śmigielski, K.; Gutarowska, B. Antimicrobial Activities of Plant Extracts against Solanum tuberosum L. Phytopathogens. Molecules 2022, 27, 1579. [Google Scholar] [CrossRef]









| Treatment mg/mL | Plates | Sporulation Status | % Sporulation | Sporulation Inhibition (%) |
|---|---|---|---|---|
| Control (−) | ![]() | NC | 0 | 100 |
| Control (+) | ![]() | C | 100 | 0 |
| 0.16 | ![]() | C | 93.905 | 6.095 |
| 0.26 | ![]() | C | 79.84 | 20.16 |
| 0.43 | ![]() | C | 38.125 | 61.875 |
| 0.73 | ![]() | C | 32.105 | 67.895 |
| 1.21 | ![]() | C | 29.685 | 70.315 |
| 2 | ![]() | C | 27.965 | 72.035 |
| 3.4 | ![]() | C | 26.795 | 73.205 |
| 5.6 | ![]() | C | 22.81 | 77.19 |
| 8 | ![]() | C | 22.105 | 77.895 |
| 15 | ![]() | C | 20.465 | 79.535 |
| 25 | ![]() | C | 19.295 | 80.705 |
| 50 | ![]() | C | 7.89 | 92.11 |
| Treatment (mg/mL) | Plates | Sporulation Status | % Sporulation | Sporulation Inhibition (%) |
|---|---|---|---|---|
| Control (−) | ![]() | NC | 0 | 100 |
| Control (+) | ![]() | C | 100 | 0 |
| 0.16 | ![]() | C | 71.641 | 28.359 |
| 0.26 | ![]() | C | 71.426 | 28.574 |
| 0.43 | ![]() | C | 52.938 | 47.062 |
| 0.73 | ![]() | C | 45.582 | 54.418 |
| 1.21 | ![]() | C | 45.166 | 54.834 |
| 2 | ![]() | C | 40.54 | 59.46 |
| 3.4 | ![]() | C | 39.706 | 60.294 |
| 5.6 | ![]() | C | 39.276 | 60.724 |
| 8 | ![]() | C | 34.234 | 65.766 |
| 15 | ![]() | C | 25.413 | 74.587 |
| 25 | ![]() | C | 22.468 | 77.532 |
| 50 | ![]() | C | 16.807 | 83.193 |
| Treatment (mg/mL) | Plates | Sporulation Status | % sporulation | Sporulation inhibition (%) |
|---|---|---|---|---|
| Control (−) | ![]() | NC | 0 | 100 |
| Control (+) | ![]() | C | 100 | 0 |
| 0.16 | ![]() | C | 93.3745 | 6.6255 |
| 0.26 | ![]() | C | 78.5628 | 21.4372 |
| 0.43 | ![]() | C | 88.137 | 11.863 |
| 0.73 | ![]() | C | 85.6806 | 14.3194 |
| 1.21 | ![]() | C | 81.1815 | 18.8185 |
| 2 | ![]() | C | 69.7218 | 30.2782 |
| 3.4 | ![]() | C | 65.7937 | 34.2063 |
| 5.6 | ![]() | C | 65.8775 | 34.1225 |
| 8 | ![]() | C | 64.8928 | 35.1072 |
| 15 | ![]() | C | 58.6759 | 41.3241 |
| 25 | ![]() | C | 44.5189 | 55.4811 |
| 50 | ![]() | C | 27.167 | 72.833 |
| Treatment mg/mL | FG % | MGR | MGT | Percentage Inhibition % |
|---|---|---|---|---|
| Effect of P. major | ||||
| 5 | 77.77 ± 7.69 | 3.37 ± 0.7 | 3.57 ± 0.55 | 22.22 ± 7.69 a |
| 10 | 26.66 ± 6.66 | 0.66 ± 0.21 | 4.66 ± 1.46 | 73.33 ± 6.66 b |
| 25 | 28.88 ± 3.84 | 0.9 ± 0.22 | 6.07 ± 1.04 | 71.11 ± 3.84 b |
| Water | 80 ± 11.54 | 2.8 ± 0.56 | 3.19 ± 0.26 | 20 ± 11.54 a |
| Negative control | 0 | 0 | 0 | 100 d |
| Effect of S. nigra | ||||
| 5 | 108.33 ± 8.33 | 4.46 ± 0.33 | 3.46 ± 0.46 | 0 a |
| 10 | 61.11 ± 4.81 | 1.56 ± 0.10 | 4.86 ± 0.55 | 38.89 ± 4.81 b |
| 25 | 0 | 0.11 ± 0.06 | 0 | 100 c |
| Water | 80 ± 11.54 | 2.8 ± 0.56 | 3.19 ± 0.26 | 20 ± 11.54 d |
| Negative control | 0 | 0 | 0 | 100 c |
| Peak | Rt (min) (PDA Detector) | λ max | Molecular Ion ([M–H]−) m/z | Fragment m/z | Putative Identification | Reference |
|---|---|---|---|---|---|---|
| 1 | 10.51 | 328, 295sh, 224 | 623 | 461, 161, 133 | Acteoside | CAS: 61276-17-3 |
| 2 | 11.18 | 327, 295sh, 218, 197 | 623 | 461, 161, 133 | Isoacteoside | CAS: 61303-13-7 |
| Peak | Rt (min) (PDA Detector) | λ max | Molecular Ion ([M–H]−) m/z | Fragment m/z | Putative Identification | Reference |
|---|---|---|---|---|---|---|
| 1 | 8.74 | Not identified | ||||
| 2 | 9.17 | 325, 295sh, 201 | 353 | 191 | Chlorogenic acid | CAS: 202650-88-2 |
| 3 | 10.55 | 328, 295sh, 224 | 623 | 461, 161, 133 | Acteoside | CAS: 61276-17-3 |
| 4 | 11.11 | 327, 295sh, 218, 197 | 623 | 461, 161, 133 | Isoacteoside | CAS: 61303-13-7 |
| 5 | 11.29 | 323, 295sh, 218 | 515 | 353, 179 | Dicaffeoylquinic acid (isomer I) | https://massbank.eu/MassBank/RecordDisplay?id=MSBNK-RIKEN_ReSpect-PM000306&dsn=RIKEN_ReSpect (accessed on 15 October 2024) |
| 6 | 11.72 | 327, 295sh, 218 | 515 | 353, 191, 179 | Dicaffeoylquinic acid (isomer II) | https://massbank.eu/MassBank/RecordDisplay?id=MSBNK-RIKEN_ReSpect-PM000306&dsn=RIKEN_ReSpect (accessed on 15 October 2024) |
| 7 | 12.42 | 327, 295sh, 218 | 515 | 371, 353, 191, 179, 173 | Dicaffeoylquinic acid (isomer III) | https://massbank.eu/MassBank/RecordDisplay?id=MSBNK-RIKEN_ReSpect-PM000306&dsn=RIKEN_ReSpect (accessed on 15 October 2024) |
Disclaimer/Publisher’s Note: The statements, opinions and data contained in all publications are solely those of the individual author(s) and contributor(s) and not of MDPI and/or the editor(s). MDPI and/or the editor(s) disclaim responsibility for any injury to people or property resulting from any ideas, methods, instructions or products referred to in the content. |
© 2025 by the authors. Licensee MDPI, Basel, Switzerland. This article is an open access article distributed under the terms and conditions of the Creative Commons Attribution (CC BY) license (https://creativecommons.org/licenses/by/4.0/).
Share and Cite
Lam-Gutiérrez, A.; Díaz-López, M.G.; Cristóbal-Alejo, J.; Ruíz-Lau, N.; Vázquez-Villegas, P.T.; Valdespino-León, M.; Rodríguez-Hernández, L. Phytotoxic and Antifungal Effects of Plantago major and Sambucus nigra Bioextracts on Key Agricultural Pathogens: Corynespora cassiicola, Fusarium oxysporum, and Penicillium oxalicum. Pathogens 2025, 14, 162. https://doi.org/10.3390/pathogens14020162
Lam-Gutiérrez A, Díaz-López MG, Cristóbal-Alejo J, Ruíz-Lau N, Vázquez-Villegas PT, Valdespino-León M, Rodríguez-Hernández L. Phytotoxic and Antifungal Effects of Plantago major and Sambucus nigra Bioextracts on Key Agricultural Pathogens: Corynespora cassiicola, Fusarium oxysporum, and Penicillium oxalicum. Pathogens. 2025; 14(2):162. https://doi.org/10.3390/pathogens14020162
Chicago/Turabian StyleLam-Gutiérrez, Anayancy, María Guadalupe Díaz-López, Jairo Cristóbal-Alejo, Nancy Ruíz-Lau, Paola Taydé Vázquez-Villegas, Mariana Valdespino-León, and Ludwi Rodríguez-Hernández. 2025. "Phytotoxic and Antifungal Effects of Plantago major and Sambucus nigra Bioextracts on Key Agricultural Pathogens: Corynespora cassiicola, Fusarium oxysporum, and Penicillium oxalicum" Pathogens 14, no. 2: 162. https://doi.org/10.3390/pathogens14020162
APA StyleLam-Gutiérrez, A., Díaz-López, M. G., Cristóbal-Alejo, J., Ruíz-Lau, N., Vázquez-Villegas, P. T., Valdespino-León, M., & Rodríguez-Hernández, L. (2025). Phytotoxic and Antifungal Effects of Plantago major and Sambucus nigra Bioextracts on Key Agricultural Pathogens: Corynespora cassiicola, Fusarium oxysporum, and Penicillium oxalicum. Pathogens, 14(2), 162. https://doi.org/10.3390/pathogens14020162